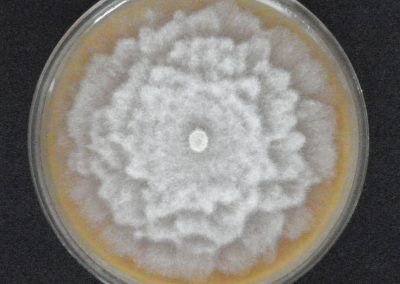

Účastníme se projektu EUPHRESCO!
VÚKOZ se zapojil do projektu PHYTO-GARD Phytophthora in public gardens: understanding pathways and mitigating risk, v rámci sítě mezinárodní spolupráce fytosanitárního výzkumu v Evropě EUPHRESCO.
Téma: Phytophthora ve veřejných zahradách: porozumění původu, cestám šíření a zmírnění rizik.
Významné veřejné zahrady a parky soustřeďují rozsáhlé, pestré a velmi cenné sbírky rostlin nashromážděné z nejrůznějších koutů světa, které jsou stále doplňovány a obměňovány. Lokální soustředění této neobvyklé a neobvykle vysoké diverzity rostlin výrazně zvyšuje riziko zavlečení a zdomácnění nových nebezpečných patogenů rodu Phytophthora, které se spolu s okrasným rostlinným materiálem šíří jako jeho kontaminace. Zavlečení taxonů těchto patogenů z různých částí světa rovněž představuje značné riziko z hlediska jejich hybridizace a vzniku nových taxonů s potenciálně značným škodlivým potenciálem. Zahrady a parky lze proto považovat za „rezervoár“ druhové rozmanitosti těchto patogenů s rizikem jejich dalšího šíření do přirozených ekosystémů. Zahrady a obecněji sbírky rostlin s rozmanitými druhy rostlin různého původu jsou tak ideálními místy pro studium společenstev fytopatogenních oomycetů, zachycení exotických druhů a zkoumání jejich hostitelských spekter a patosystémů. V těchto ohledech mohou být zahrady považovány za ideální „hlídací“ místa v systémech monitorování a fytosanitárního dohledu.
Cíle projektu:
1) Identifikovat nejrozšířenější druhy Phytophthora ve veřejných zahradách a zhodnotit potenciální riziko pro sbírky rostlin v zahradách.
2) Pochopit cesty introdukce a vyhodnotit rizika zavlečení druhů rodu Phytophthora do veřejných zahrad prostřednictvím příchozího sadebního materiálu.
3) Vylepšit stávající metodu metabarcodingu zkoumáním nových molekulární technologií pro lepší rozlišení druhů.
4) Zvyšování povědomí o riziku zavlékání patogenů rodu Phytophthora u manažerů zahrad a dodavatelů zásobních rostlin, v zahradnických a vědeckých komunitách.
Projektu se účastní Odbor biologických rizik (Markéta Hrabětová, Karel Černý) ve spolupráci s Dendrologickou zahradou (Zdeněk Kiesenbauer) a Průhonickým parkem (Jiří Burda).
Doba trvání projektu: 30/05/2023-30/05/2025